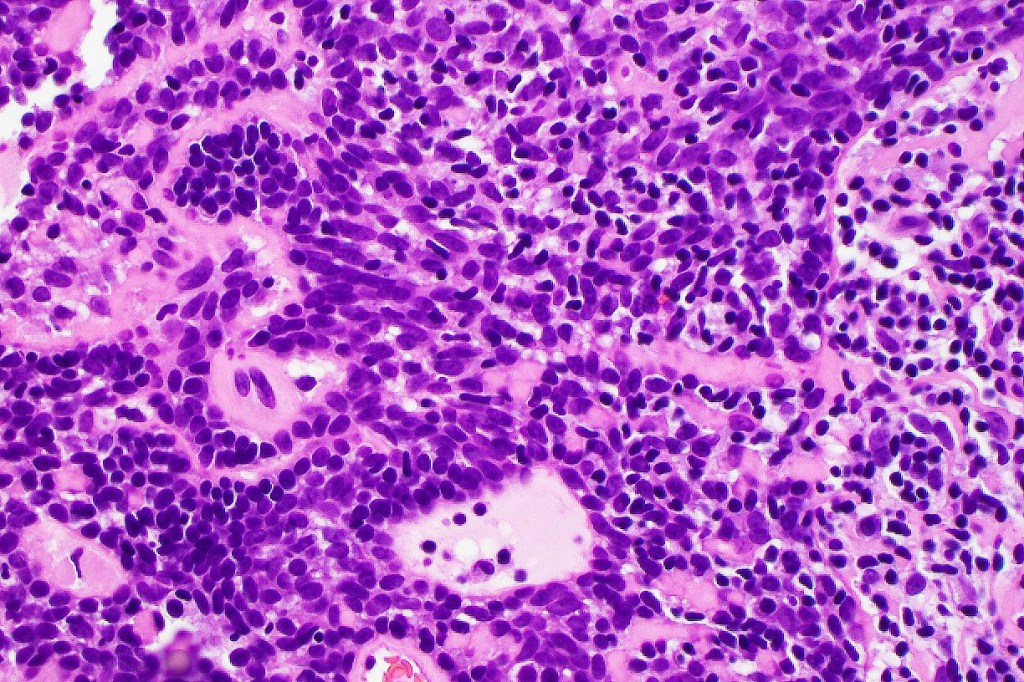
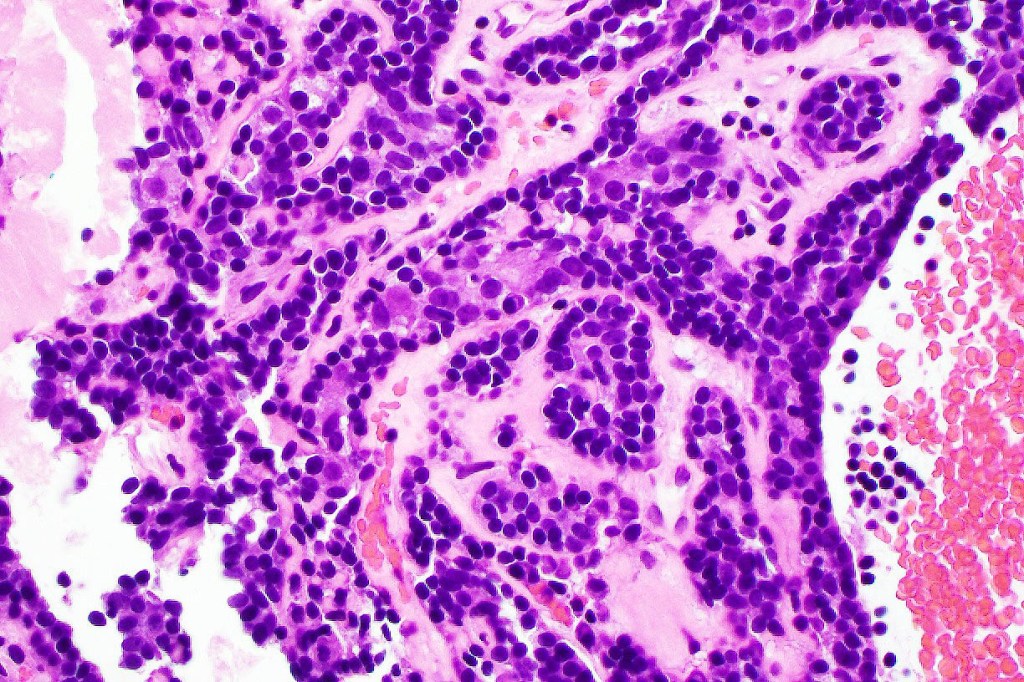
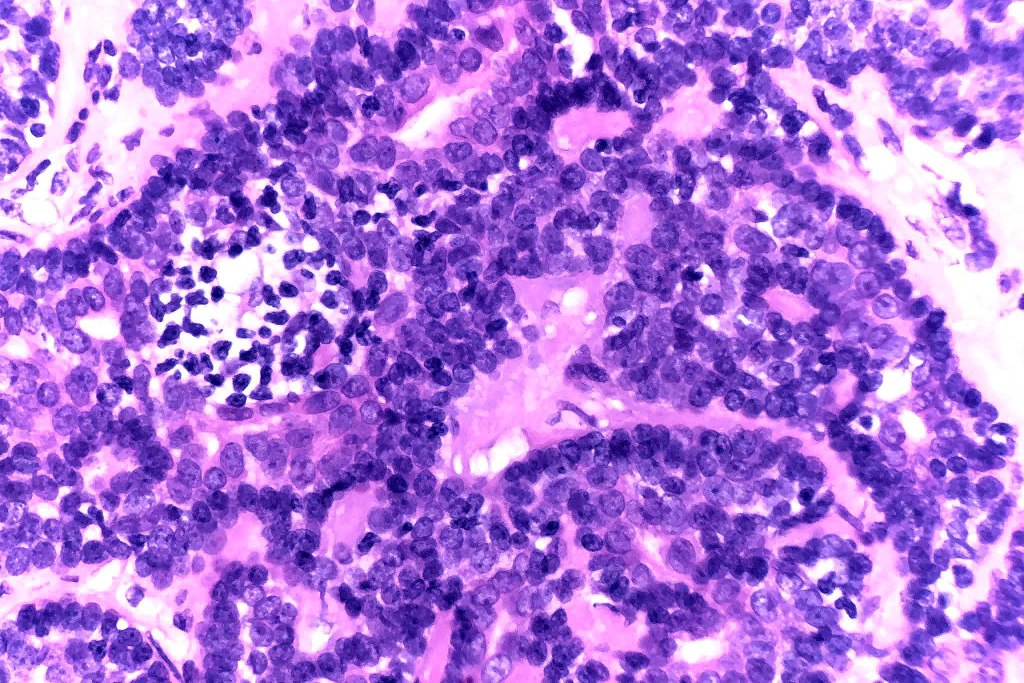

Clinical features
•Tender or painful, sharply delineated typically blue 1-3 cm dermal nodule nodule
•Ventral skin, most on the upper half of the integument (head, neck & trunk)
•Rarely multiple lesions
2nd-4th decade
•Giant variant
•Linear, Blaschkoid, variants
•Autosomal dominant familial variant
•May occur as part of the Brooke-Spiegler syndrome

Histological features
•Nodule/multiple blue encapsulated nodules in the dermis +/- subcutaneous fat
•Common association with an adjacent nerve & exceptional intraneural component
•Outer layer of small intensely basophilic cells surrounding larger pale staining or eosinophilic cells with vesicular nuclei & small nucleoli
•Intra-tumoral lymphocytes
•Ductal & exceptionally, glandular differentiation
•Cystic variant
•Exceptionally, adenoid cystic carcinoma-like features
•No pleomorphism & only sparse mitoses or no mitoses
•Basement membrane thickening & intralobular eosinophilic globules
•Exceptionally sebaceous differentiation
•Marked lymphedema sometimes present- lymphangiectatic variant
•Spiradenocylindroma
•Telangiectatic variant
•Association with trichoepithelioma & trichoblastoma
•The tumor is so distinctive that IHC is rarely necessary- EMA & CEA highlight ductal/glandular differentiation, CK7 & β catenin +ve, myoepithelial cells- SMA & S100 +ve

Leave a comment